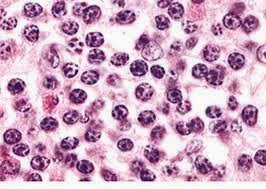

Waardenburg
Syndrome
Waardenburg
Syndrome is a rare genetic disorder that involves deafness, facial
abnormalities and pale skin, hair and eye color. The condition is usually
inherited as an autosominal dominant trait. There are four types of Waardenburg
Syndrome classified as Type 1, Type 2, Type 3 and Type 4, the latter 2 are
rarer.
Symptoms
–
Symptoms
includes, hearing loss, extremely pale eye color, graying of hair, wide-set
eyes, slight intellectual disability, constipation, broad nasal root.
Diagnosis
& Treatment –
Diagnosis
is done by colon biopsy, genetic testing, audiometry and bowel transit time.
There is no known cure for Waardenburg Syndrome; patients are treated according
to the symptoms. Hearing loss is treated as any other irreversible deafness,
special diets are recommended for regular bowel movement.

A little note to let everybody know about the powerful work of doctor chimnedum herbal home. My name is Gazalee from Malaysia and i was ones a HEPATITIS and HBP victim until i read about Dr chimnedum herbal home online on how he cured so many people with herbal remedies,and i contacted him for help and he really helped, after i applied his herbal remedies. i am testifying to this great Dr chimnedum herbal home because i want everybody to be informed so that you will contact him today for your cure, Contact him through: dr.chimnedumherbalhome1616@gmail.com Call/Whatsapp: +2347086675538,I'm healed,
ReplyDeleteis a great thing in my life today.